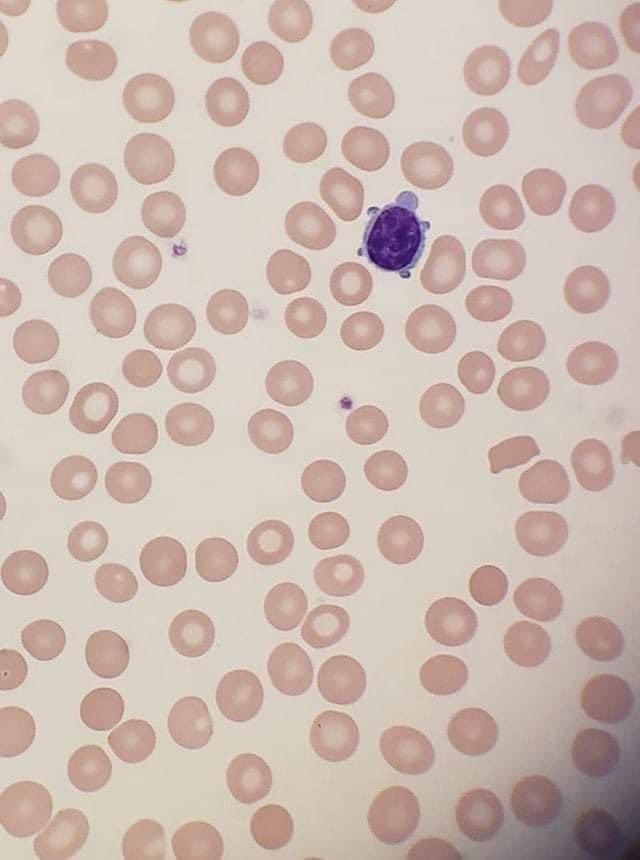
Hafsa Nebbache, MD tweet media

Kayla Hackman retweetledi

We are excited to announce that the Diagnostics & Research Institute for Pathology at @MedUniGraz has selected HALO AP® to deliver primary diagnostics!
Read our press release to learn: indicalab.com/news/medical-u…
#DigitalPathology #PathX #PathTwitter #TissueAnalysis #PathologyLab
English